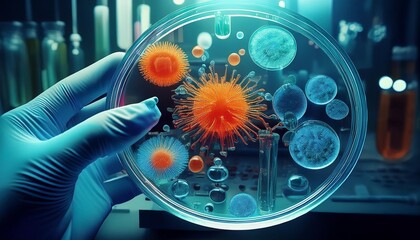
3d rendered illustration of a dna

- Home >
- Stock Photos >
- Digital Clock and DNA Strand with Binary Code Background
Digital Clock and DNA Strand with Binary Code Background Image

Dynamic visual representation of time intersecting with technological elements like DNA and binary code. Ideal for concepts related to time in technology, digital transformation in biology, and the interplay between genetics and technology. Perfect for use in articles, presentations, and content surrounding advanced scientific research or digital innovation.
downloads
Tags:
More
Credit Photo
If you would like to credit the Photo, here are some ways you can do so
Text Link
photo Link
<span class="text-link">
<span>
<a target="_blank" href=https://pikwizard.com/photo/digital-clock-and-dna-strand-with-binary-code-background/abfd9e21dc4b39a157fb9e57af0e4dcd/>PikWizard</a>
</span>
</span>
<span class="image-link">
<span
style="margin: 0 0 20px 0; display: inline-block; vertical-align: middle; width: 100%;"
>
<a
target="_blank"
href="https://pikwizard.com/photo/digital-clock-and-dna-strand-with-binary-code-background/abfd9e21dc4b39a157fb9e57af0e4dcd/"
style="text-decoration: none; font-size: 10px; margin: 0;"
>
<img src="https://pikwizard.com/pw/medium/abfd9e21dc4b39a157fb9e57af0e4dcd.jpg" style="margin: 0; width: 100%;" alt="" />
<p style="font-size: 12px; margin: 0;">PikWizard</p>
</a>
</span>
</span>
Free (free of charge)
Free for personal and commercial use.
Author: Authentic Images